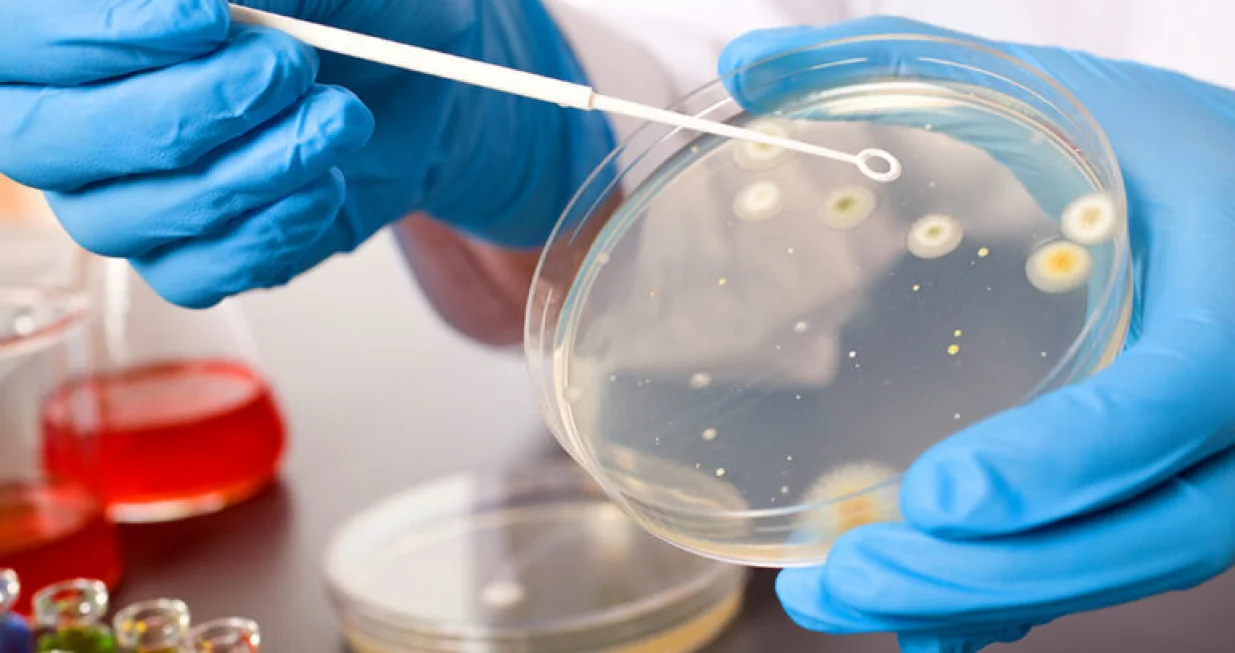
zdravstveno istraživanje/

Poljubac insekta sa smrtonosnim posljedicama: Šta znamo o Čagasovoj bolesti
Ilustracija
U radu objavljenom ovog mjeseca u časopisu Emerging Infectious Diseases, američki stručnjaci za javno zdravlje naveli su da bi bolest trebalo smatrati endemskom i u SAD-u. Ukazali su na prisutnost insekata i zaraženih životinja, kao i na stalne lokalne slučajeve kod ljudi u Teksasu u periodu od 2013. do 2023. godine.
Triatoma insekti, poznati kao „poljubac insekti“, hrane se krvlju i najčešće grizu lice, što im je i donijelo nadimak. Oko polovine njih nosi parazita koji uzrokuje Čagasovu bolest. Infekcija se prenosi kada insekt obavi nuždu u blizini ugriza; češanjem ili trljanjem zaraženi materijal ulazi u organizam.
Jednom kada dođe do zaraze, infekcija najčešće traje cijeli život. Većina oboljelih nema simptome i možda nikada neće saznati da su zaraženi. Ipak, kod 20 do 30 posto zaraženih razvijaju se ozbiljne komplikacije, uključujući srčanu insuficijenciju.
Prema procjenama Centra za kontrolu i prevenciju bolesti (CDC), oko 8 miliona ljudi u svijetu živi s ovom bolešću, a u SAD-u je 2022. godine zaraženo oko 288.000 osoba. Samo oko 10.000 njih zarazilo se unutar zemlje, dok je većina došla iz Latinske Amerike.
Poljubac insekti zabilježeni su u 32 savezne države, a lokalni slučajevi potvrđeni su u njih osam – uključujući Kaliforniju, Teksas i Arizonu. Uprkos tome, stručnjaci naglašavaju da je rizik za većinu Amerikanaca izuzetno nizak.
U ranoj fazi infekcija može izazvati groznicu, umor i simptome slične gripi. Kod nekih se javlja oticanje kapka. Simptomi najčešće spontano nestaju, a bolest se često otkriva tek prilikom dobrovoljnog davanja krvi. Samo jedan posto oboljelih bude dijagnosticiran.
Oko 70 posto zaraženih nikada ne razvije ozbiljne posljedice, dok kod ostalih bolest može dovesti do teških srčanih komplikacija, pa i iznenadne smrti. Postoje dva lijeka koja uništavaju parazita, a najefikasniji su ako se počnu primjenjivati odmah nakon infekcije.
Insekti često ulaze u kuće, pseće kaveze ili lovačke kućice. Rizik se može smanjiti ugradnjom mreža na prozore i vrata, zatvaranjem pukotina i uklanjanjem otpada oko kuće. U slučaju da se insekt pronađe, može se poslati na testiranje na Texas A&M Univerzitet ili državnim zdravstvenim institucijama.
Ako neko iz porodice oboli, preporučuje se testiranje svih članova, posebno žena u reproduktivnoj dobi, budući da se bolest može prenijeti s majke na dijete tokom trudnoće, piše N1.



















